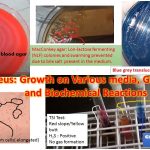
Proteus: Growth on Various media, Gram Stain and Biochemical Reactions

Tag: Proteus mirabilis
Proteus: General Characteristics, Morphology, Pathogenecity, Laboratory Diagnosis and Keynotes
 Proteus General Characteristic Proteus species are Gram-negative rods and facultative anaerobes....
Proteus General Characteristic Proteus species are Gram-negative rods and facultative anaerobes....
Proteus General Characteristic Proteus species are Gram-negative rods and facultative anaerobes....
Proteus General Characteristic Proteus species are Gram-negative rods and facultative anaerobes....